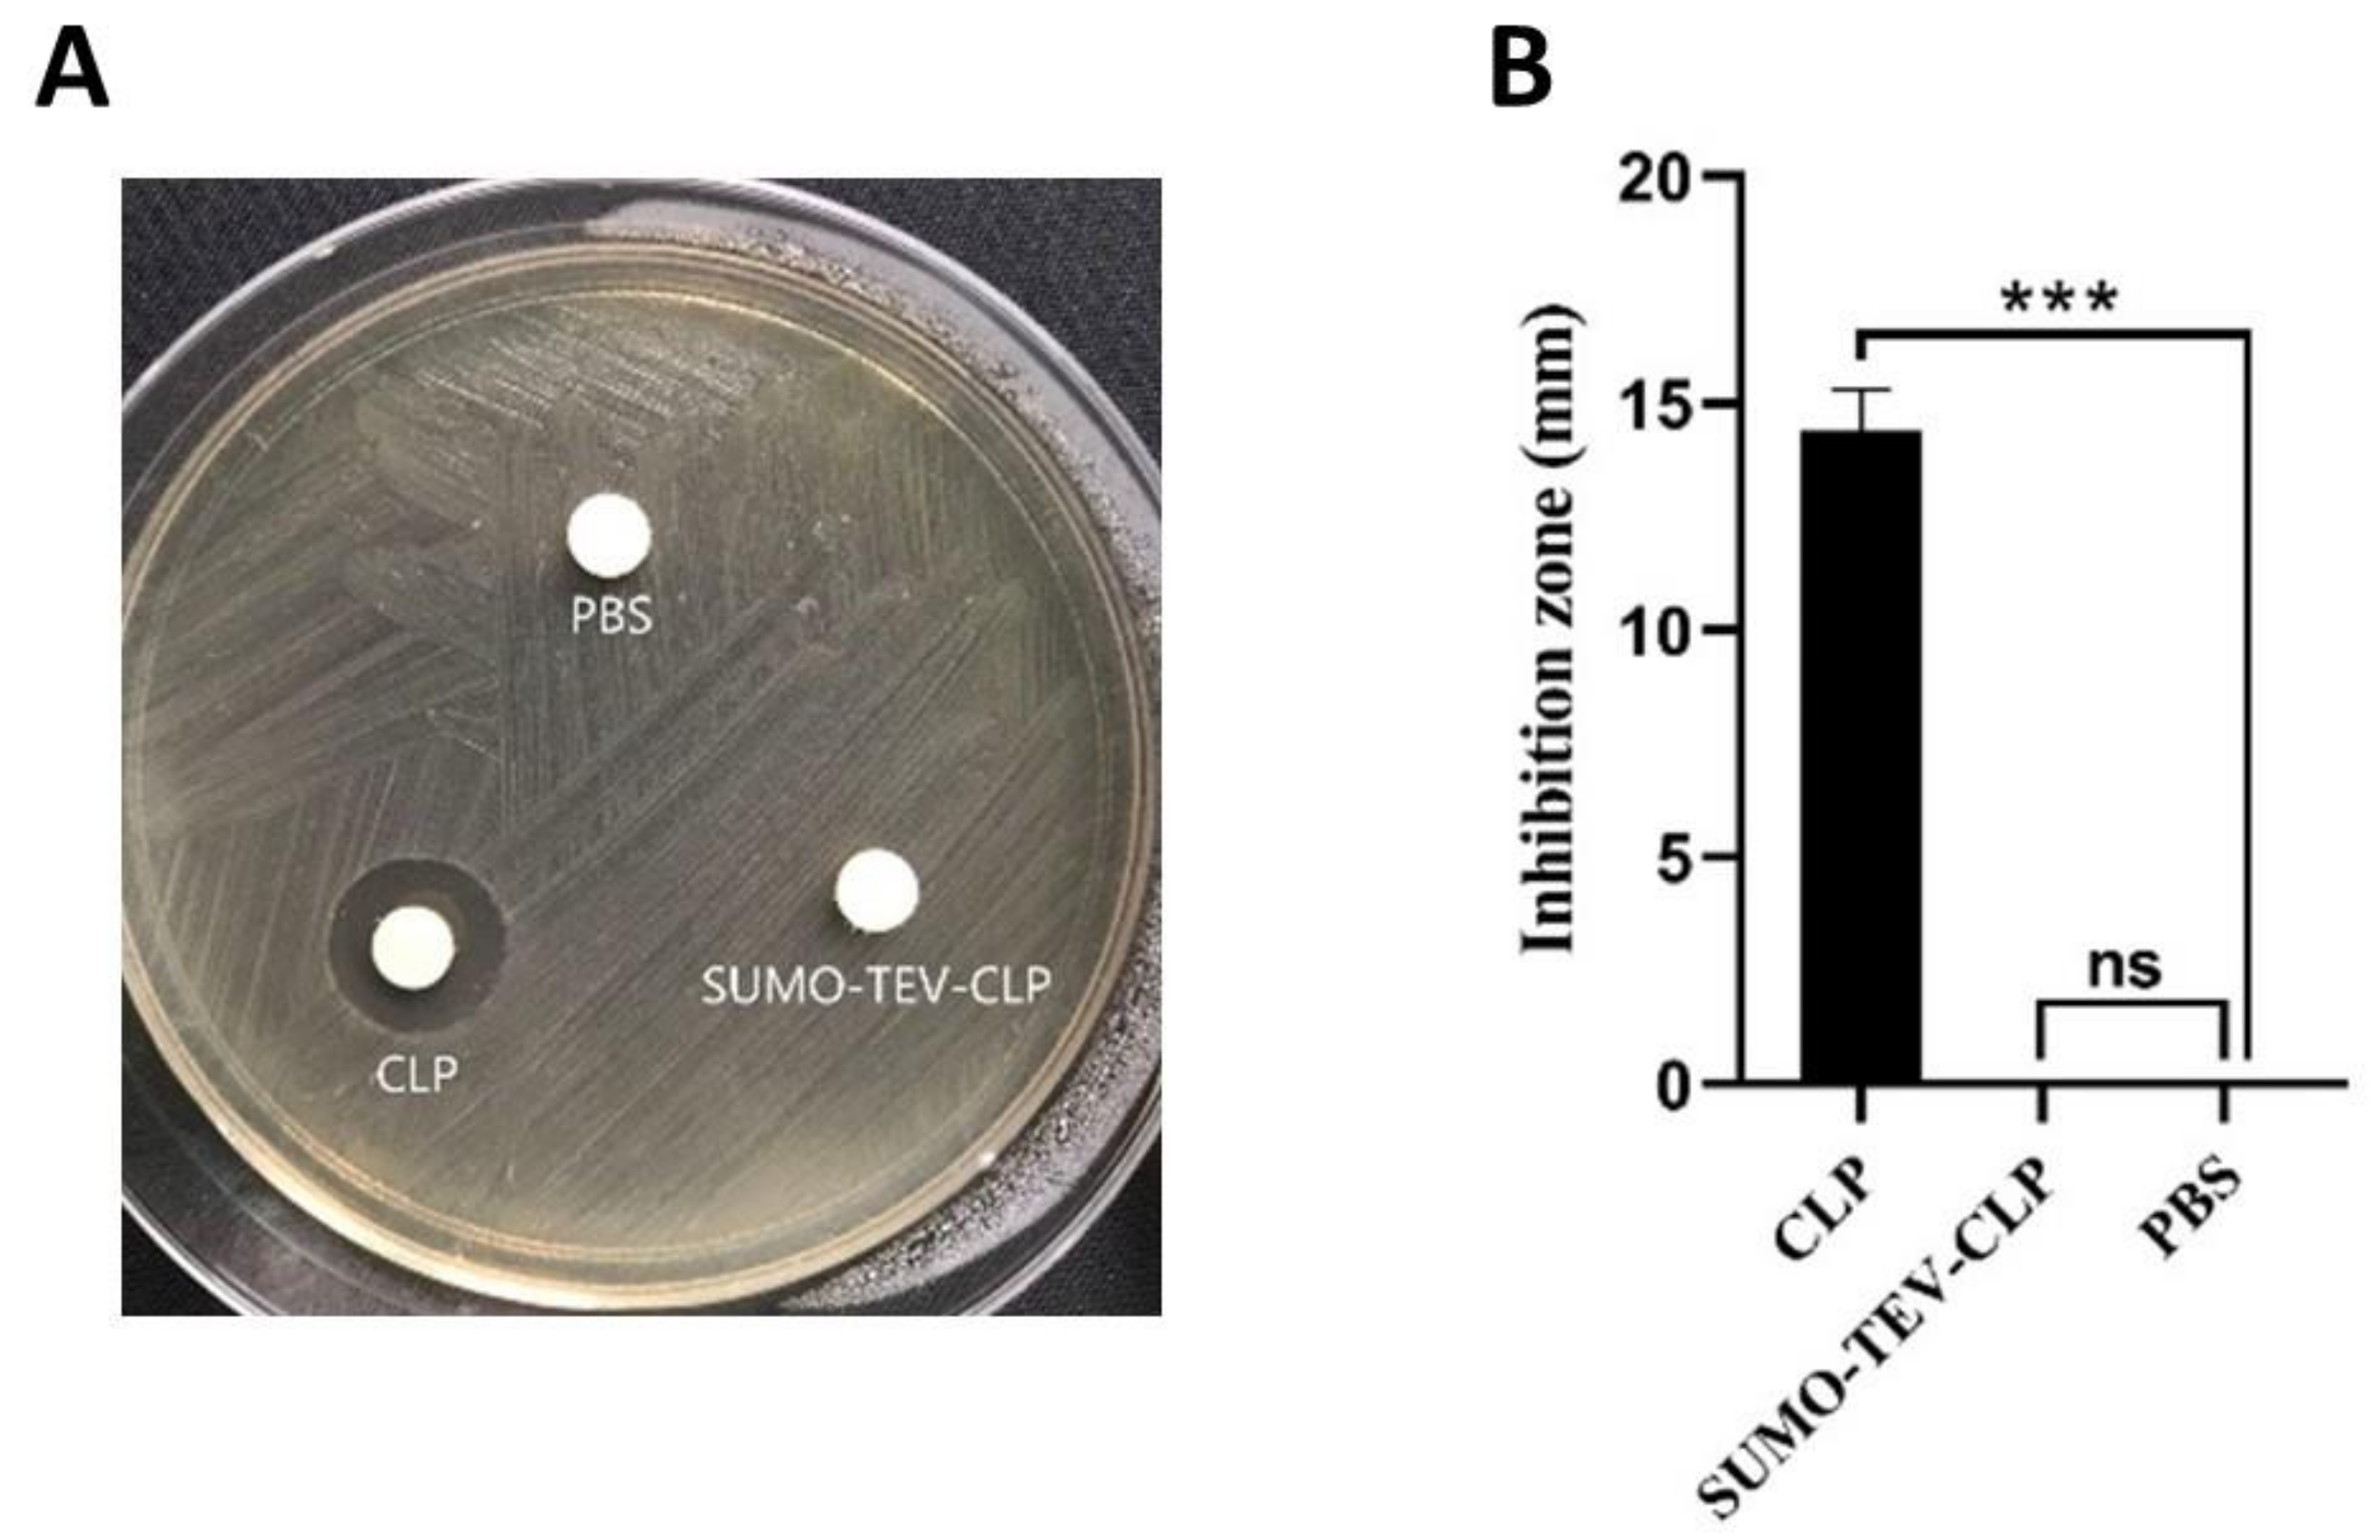
Molecules 26 07142 g003 Molecules 26 07142 g003

Expression, Purification and Characterization of a Novel Hybrid Peptide CLP with Excellent Antibacterial Activity
Abstract
1. Introduction
2. Results
2.1. Construction of Recombinant Expression Plasmids
2.2. Expression of SUMO-TEV-CLP
2.3. Purification and Cleavage of SUMO-TEV-CLP
2.4. Purification of Recombinant CLP
2.5. Antimicrobial Activities of CM4, LL37, TP5, Recombinant CLP(rCLP) and Synthesized CLP (sCLP)
2.6. Recombinant CLP Induces Bacterial Membrane Permeabilization
2.7. Effect of pH, Temperature, and Proteinases on Recombinant CLP Activity
2.8. Hemolytic Activity of CLP
3. Discussion
4. Materials and Methods
4.1. Strains and Plasmid
4.2. Regents and Enzymes
4.3. Synthesis of CLP
4.4. Construction of Expression Vectors
4.5. Expression of SUMO-TEV-CLP
4.6. Purification of SUMO-TEV-CLP
4.7. Cleavage and Purification of the Recombinant CLP
4.8. Antibacterial Activity
4.8.1. Inhibition Zone
4.8.2. Minimal Inhibitory Concentrations
4.8.3. Propidium Iodide Uptake
4.8.4. Scanning Electron Microscopy
4.9. Stability Assessment of CLP
4.10. Hemolytic Assay
5. Conclusions
Supplementary Materials
Author Contributions
Funding
Institutional Review Board Statement
Informed Consent Statement
Data Availability Statement
Acknowledgments
Conflicts of Interest
Sample Availability
References
- Wei, X.B.; Wu, R.Z.; Zhang, L.L.; Ahmad, B.; Si, D.Y.; Zhang, R.J. Expression, Purification, and Characterization of a Novel Hybrid Peptide with Potent Antibacterial Activity. Molecules 2018, 23, 1491. [Google Scholar] [CrossRef]
- Li, Z.X.; Cheng, Q.; Guo, H.N.; Zhang, R.J.; Si, D.Y. Expression of Hybrid Peptide EF-1 in Pichia pastoris, Its Purification, and Antimicrobial Characterization. Molecules 2020, 25, 5538. [Google Scholar] [CrossRef]
- Wei, X.B.; Wu, R.J.; Si, D.Y.; Liao, X.D.; Zhang, L.L.; Zhang, R.J. Novel Hybrid Peptide Cecropin A (1–8)-LL37 (17–30) with Potential Antibacterial Activity. Int. J. Mol. Sci. 2016, 17, 983. [Google Scholar] [CrossRef]
- Santos-Filho, N.A.; Fernandes, R.S.; Sgardioli, B.F.; Ramos, M.A.S.; Piccoli, J.P.; Camargo, I.; Bauab, T.M.; Cilli, E.M. Antibacterial Activity of the Non-Cytotoxic Peptide (p-BthTX-I)(2) and Its Serum Degradation Product against Multidrug-Resistant Bacteria. Molecules 2017, 22, 1898. [Google Scholar] [CrossRef]
- Lazzaro, B.P.; Zasloff, M.; Rolff, J. Antimicrobial peptides: Application informed by evolution. Science 2020, 368, 487. [Google Scholar] [CrossRef]
- Magana, M.; Pushpanathan, M.; Santos, A.L.; Leanse, L.; Fernandez, M.; Ioannidis, A.; Giulianotti, M.A.; Apidianakis, Y.; Bradfute, S.; Ferguson, A.L.; et al. The value of antimicrobial peptides in the age of resistance. Lancet Infect. Dis. 2020, 20, e216–e230. [Google Scholar] [CrossRef]
- Hwang, P.M.; Vogel, H.J. Structure-function relationships of antimicrobial peptides. Biochem. Cell Biol. 1998, 76, 235–246. [Google Scholar] [CrossRef] [PubMed]
- Shah, Y.; Sehgal, D.; Valadi, J.K. Recent trends in antimicrobial peptide prediction using machine learning techniques. Bioinformation 2017, 13, 415. [Google Scholar] [CrossRef][Green Version]
- Lai, Y.; Gallo, R.L. AMPed up immunity: How antimicrobial peptides have multiple roles in immune defense. Trends Immunol. 2009, 30, 131–141. [Google Scholar] [CrossRef]
- Pantic, J.M.; Jovanovic, I.P.; Radosavljevic, G.D.; Arsenijevic, N.N.; Conlon, J.M.; Lukic, M.L. The Potential of Frog Skin-Derived Peptides for Development into Therapeutically-Valuable Immunomodulatory Agents. Molecules 2017, 22, 2071. [Google Scholar]
- Benfield, A.H.; Henriques, S.T. Mode-of-Action of Antimicrobial Peptides: Membrane Disruption vs. Intracellular Mechanisms. Front. Med. 2020, 2, 20. [Google Scholar] [CrossRef]
- Brogden, K.A. Antimicrobial peptides: Pore formers or metabolic inhibitors in bacteria? Nat. Rev. Microbiol. 2005, 3, 238–250. [Google Scholar] [CrossRef] [PubMed]
- Yang, L.; Harroun, T.A.; Weiss, T.M.; Ding, L.; Huang, H.W. Barrel-stave model or toroidal model? A case study on melittin pores. Biophys. J. 2001, 81, 1475–1485. [Google Scholar] [CrossRef]
- Sengupta, D.; Leontiadou, H.; Mark, A.E.; Marrink, S.J. Toroidal pores formed by antimicrobial peptides show significant disorder. Biochim. Biophys. Acta 2008, 1778, 2308–2317. [Google Scholar] [CrossRef] [PubMed]
- Zhou, L.; Lin, Q.; Li, B.; Li, N.; Zhang, S. Expression and purification the antimicrobial peptide CM4 in Escherichia coli. Biotechnol. Lett. 2009, 31, 437–441. [Google Scholar] [CrossRef]
- Li, J.F.; Zhang, J.; Zhang, Z.; Kang, C.T.; Zhang, S.Q. SUMO mediating fusion expression of antimicrobial peptide CM4 from two joined genes in Escherichia coli. Curr. Microbiol. 2011, 62, 296–300. [Google Scholar] [CrossRef] [PubMed]
- Li, J.F.; Zhang, J.X.; Li, G.; Xu, Y.Y.; Lu, K.; Wang, Z.G.; Liu, J.P. Antimicrobial activity and mechanism of peptide CM4 against Pseudomonas aeruginosa. Food Funct. 2020, 11, 7245–7254. [Google Scholar] [CrossRef]
- Ramos, R.; Silva, J.P.; Rodrigues, A.C.; Costa, R.; Guardao, L.; Schmitt, F.; Soares, R.; Vilanova, M.; Domingues, L.; Gama, M. Wound healing activity of the human antimicrobial peptide LL37. Peptides 2011, 32, 1469–1476. [Google Scholar] [CrossRef] [PubMed]
- Wang, G.; Mishra, B.; Epand, R.F.; Epand, R.M. High-quality 3D structures shine light on antibacterial, anti-biofilm and antiviral activities of human cathelicidin LL-37 and its fragments. Biochim. Biophys. Acta 2014, 1838, 2160–2172. [Google Scholar] [CrossRef]
- Thennarasu, S.; Tan, A.; Penumatchu, R.; Shelburne, C.E.; Heyl, D.L.; Ramamoorthy, A. Antimicrobial and membrane disrupting activities of a peptide derived from the human cathelicidin antimicrobial peptide LL37. Biophys. J. 2010, 98, 248–257. [Google Scholar] [CrossRef]
- Goldstein, G.; Scheid, M.P.; Boyse, E.A.; Schlesinger, D.H.; Van Wauwe, J. A synthetic pentapeptide with biological activity characteristic of the thymic hormone thymopoietin. Science 1979, 204, 1309–1310. [Google Scholar] [PubMed]
- Henriques-Coelho, T.; Oliveira, S.M.; Moura, R.S.; Roncon-Albuquerque, R., Jr.; Neves, A.L.; Santos, M.; Nogueira-Silva, C.; La Fuente Carvalho, F.; Brandao-Nogueira, A.; Correia-Pinto, J.; et al. Thymulin inhibits monocrotaline-induced pulmonary hypertension modulating interleukin-6 expression and suppressing p38 pathway. Endocrinology 2008, 149, 4367–4373. [Google Scholar] [CrossRef] [PubMed][Green Version]
- Zhang, L.L.; Wei, X.B.; Zhang, R.J.; Si, D.Y.; Petitte, J.N.; Ahmad, B.; Zhang, M.Y. A Novel Peptide Ameliorates LPS-Induced Intestinal Inflammation and Mucosal Barrier Damage via Its Antioxidant and Antiendotoxin Effects. Int. J. Mol. Sci. 2019, 20, 3974. [Google Scholar] [CrossRef] [PubMed]
- Tan, T.T.; Wu, D.; Li, W.Z.; Zheng, X.; Li, W.F.; Shan, A.S. High Specific Selectivity and Membrane-Active Mechanism of Synthetic Cationic Hybrid Antimicrobial Peptides Based on the Peptide FV7. Int. J. Mol. Sci. 2017, 18, 339. [Google Scholar] [CrossRef]
- Fox, M.A.; Thwaite, J.E.; Ulaeto, D.O.; Atkins, T.P.; Atkins, H.S. Design and characterization of novel hybrid antimicrobial peptides based on cecropin A, LL-37 and magainin II. Peptides 2012, 33, 197–205. [Google Scholar] [CrossRef] [PubMed]
- Saugar, J.M.; Rodriguez-Hernandez, M.J.; de la Torre, B.G.; Pachon-Ibanez, M.E.; Fernandez-Reyes, M.; Andreu, D.; Pachon, J.; Rivas, L. Activity of cecropin A-melittin hybrid peptides against colistin-resistant clinical strains of Acinetobacter baumannii: Molecular basis for the differential mechanisms of action. Antimicrob. Agents Chemother. 2006, 50, 1251–1256. [Google Scholar] [CrossRef] [PubMed]
- Ingham, A.B.; Moore, R.J. Recombinant production of antimicrobial peptides in heterologous microbial systems. Biotechnol. Appl. Biochem. 2007, 47, 1–9. [Google Scholar]
- Li, Y.F.; Chen, Z.X. RAPD: A database of recombinantly-produced antimicrobial peptides. FEMS Microbiol. Lett 2008, 289, 126–129. [Google Scholar] [CrossRef]
- Li, Y.F. Recombinant production of antimicrobial peptides in Escherichia coli: A review. Protein Expr. Purif. 2011, 80, 260–267. [Google Scholar] [CrossRef] [PubMed]
- Wu, G.Q.; Li, L.X.; Ding, J.X.; Wen, L.Z.; Shen, Z.L. High-level expression and novel purification strategy of recombinant thanatin analog in Escherichia coli. Curr. Microbiol. 2008, 57, 95–101. [Google Scholar] [CrossRef] [PubMed]
- Bommarius, B.; Jenssen, H.; Elliott, M.; Kindrachuk, J.; Pasupuleti, M.; Gieren, H.; Jaeger, K.E.; Hancock, R.E.; Kalman, D. Cost-effective expression and purification of antimicrobial and host defense peptides in Escherichia coli. Peptides 2010, 31, 1957–1965. [Google Scholar] [CrossRef]
- Bayarbat, I.; Lee, J.H.; Lee, S.Y. Expression of Recombinant Hybrid Peptide Gaegurin4 and LL37 using Fusion Protein in E. coli. Microbiol. Biotechnol. Lett. 2012, 40, 92–97. [Google Scholar] [CrossRef]
- Zhou, L.X.; Liu, Z.Y.; Xu, G.Y.; Li, L.H.; Xuan, K.A.; Xu, Y.; Zhang, R.Z. Expression of Melittin in Fusion with GST in Escherichia coli and Its Purification as a Pure Peptide with Good Bacteriostatic Efficacy. ACS Omega 2020, 5, 9251–9258. [Google Scholar] [CrossRef] [PubMed]
- Wibowo, D.; Zhao, C.X. Recent achievements and perspectives for large-scale recombinant production of antimicrobial peptides. Appl. Microbiol. Biotechnol. 2019, 103, 659–671. [Google Scholar] [CrossRef] [PubMed]
- Elhag, O.; Zhou, D.Z.; Song, Q.; Soomro, A.A.; Cai, M.M.; Zheng, L.Y.; Yu, Z.N.; Zhang, J.B. Screening, expression, purification and functional characterization of novel antimicrobial peptide genes from Hermetia illucens (L.). PLoS ONE 2017, 12, e0169582. [Google Scholar] [CrossRef] [PubMed]
- Kim, D.S.; Kim, S.W.; Song, J.M.; Kim, S.Y.; Kwon, K.C. A new prokaryotic expression vector for the expression of antimicrobial peptide abaecin using SUMO fusion tag. BMC Biotechnol. 2019, 19, 1–12. [Google Scholar] [CrossRef] [PubMed]
- Cheng, J.H.; Wu, M.K.; Zhong, R.; Si, D.Y.; Meng, G.; Zhang, R.J.; Zhang, Y.P. Rapid Golden Gate assembly of exons from genomic DNA for protein expression in Escherichia coli and Pichia pastoris. BioTechniques 2021, 71, 440–450. [Google Scholar] [CrossRef] [PubMed]
- Koro, C.; Hellvard, A.; Delaleu, N.; Binder, V.; Scavenius, C.; Bergum, B.; Główczyk, I.; Roberts, H.M.; Chapple, I.L.; Grant, M.M.; et al. Carbamylated LL-37 as a modulator of the immune response. Innate Immun. 2016, 22, 218–229. [Google Scholar] [CrossRef]
- De Grado, W.F.; Musso, G.F.; Lieber, M.; Kaiser, E.T.; Kezdy, F.J. Kinetics and mechanism of hemolysis induced by melittin and by a synthetic melittin analogue. Biophys. J. 1982, 37, 329–338. [Google Scholar] [CrossRef]
- Kosobokova, E.N.; Skrypnik, K.A.; Kosorukov, V.S. Overview of fusion tags for recombinant proteins. Biochemistry 2016, 81, 187–200. [Google Scholar]
- Cao, J.; de la Fuente-Nunez, C.; Ou, R.W.; Torres, M.T.; Pande, S.G.; Sinskey, A.J.; Lu, T.K. Yeast-Based Synthetic Biology Platform for Antimicrobial Peptide Production. ACS Synth. Biol. 2018, 7, 896–902. [Google Scholar] [CrossRef] [PubMed]
- Esposito, D.; Chatterjee, D.K. Enhancement of soluble protein expression through the use of fusion tags. Curr. Opin. Biotechnol. 2006, 17, 353–358. [Google Scholar] [CrossRef] [PubMed]
- Wu, M.; Hancock, R.E. Interaction of the cyclic antimicrobial cationic peptide bactenecin with the outer and cytoplasmic membrane. J. Biol. Chem. 1999, 274, 29–35. [Google Scholar] [CrossRef]
- Yi, T.; Sun, S.; Huang, Y.; Chen, Y. Prokaryotic expression and mechanism of action of alpha-helical antimicrobial peptide A20L using fusion tags. BMC Biotechnol. 2015, 15, 69. [Google Scholar] [CrossRef] [PubMed]
- Moon, J.Y.; Henzler-Wildman, K.A.; Ramamoorthy, A. Expression and purification of a recombinant LL-37 from Escherichia coli. Biochim. Biophys. Acta 2006, 1758, 1351–1358. [Google Scholar] [CrossRef] [PubMed]
- Snoeck, V.; Cox, E.; Verdonck, F.; Joensuu, J.J.; Goddeeris, B.M. Influence of porcine intestinal pH and gastric digestion on antigenicity of F4 fimbriae for oral immunisation. Vet. Microbiol. 2004, 98, 45–53. [Google Scholar] [CrossRef] [PubMed]
- Low, A.G. The activity of pepsin, chymotrypsin and trypsin during 24 h periods in the small intestine of growing pigs. Br. J. Nutr. 1982, 48, 147–159. [Google Scholar] [CrossRef]

| Indicated Strains | MIC (µg/mL) | ||||
|---|---|---|---|---|---|
| LL37 | CM4 | TP5 | rCLP | sCLP | |
| P.aeruginosa 337005 | 32 | 32 | >512 | 2 | 2 |
| S. aureus 1882 | 32 | 256 | >512 | 8 | 8 |
| ETEC K88 | 16 | 8 | >512 | 2 | 2 |
Publisher’s Note: MDPI stays neutral with regard to jurisdictional claims in published maps and institutional affiliations. |
© 2021 by the authors. Licensee MDPI, Basel, Switzerland. This article is an open access article distributed under the terms and conditions of the Creative Commons Attribution (CC BY) license (https://creativecommons.org/licenses/by/4.0/).
Share and Cite
Cheng, J.; Ahmat, M.; Guo, H.; Wei, X.; Zhang, L.; Cheng, Q.; Zhang, J.; Wang, J.; Si, D.; Zhang, Y.; et al. Expression, Purification and Characterization of a Novel Hybrid Peptide CLP with Excellent Antibacterial Activity. Molecules 2021, 26, 7142. https://doi.org/10.3390/molecules26237142
Cheng J, Ahmat M, Guo H, Wei X, Zhang L, Cheng Q, Zhang J, Wang J, Si D, Zhang Y, et al. Expression, Purification and Characterization of a Novel Hybrid Peptide CLP with Excellent Antibacterial Activity. Molecules. 2021; 26(23):7142. https://doi.org/10.3390/molecules26237142
Chicago/Turabian StyleCheng, Junhao, Marhaba Ahmat, Henan Guo, Xubiao Wei, Lulu Zhang, Qiang Cheng, Jing Zhang, Junyong Wang, Dayong Si, Yueping Zhang, and et al. 2021. "Expression, Purification and Characterization of a Novel Hybrid Peptide CLP with Excellent Antibacterial Activity" Molecules 26, no. 23: 7142. https://doi.org/10.3390/molecules26237142
APA StyleCheng, J., Ahmat, M., Guo, H., Wei, X., Zhang, L., Cheng, Q., Zhang, J., Wang, J., Si, D., Zhang, Y., & Zhang, R. (2021). Expression, Purification and Characterization of a Novel Hybrid Peptide CLP with Excellent Antibacterial Activity. Molecules, 26(23), 7142. https://doi.org/10.3390/molecules26237142

